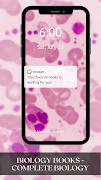
Biology Textbook تصوير الشاشة 2

عن Biology Textbook
دورة علم الأحياء التمهيدية هي دورة مصممة للطلاب
This app will try to explore some of the most interesting Biology topics and related issues that are happening in the world. We will also try to give you some brief overviews on them. This will be an interesting journey, and we hope you enjoy yourselves with us, while we explore this exciting science field.
As biology tutor, I've been helping students grasp the basics of biology for a long time. In this article, I'm going to share with you some of the most interesting biology topics that you can cover during your biology lessons. Hopefully, these topics will serve as guides for you as you prepare for your biology exam.
Download free biology courses and become a more knowledgeable biologist. Biology is the science of life and living things, as well as all of the processes and mechanisms that support life. It is a natural science concerned with the characteristics, classification and behavior of organisms, as well as how species were formed and their interactions with each other and the environment.
Biology is the study of life and living organisms. It encompasses a variety of scientific disciplines and is taught in colleges, universities, and laboratories around the world. As a biology major, you'll learn how different organisms work, how to identify them, how they grow and change over time, and how we can use them to benefit humanity. Biology majors also have a solid grasp of the scientific method and other analytical methods used in research.
Our body contains many biological materials that are often the target of a large number of diseases. However, they may also be used as a trigger for healing. The use of biological materials has a major impact on human health, animal health and environmental protection. Biomaterials can be divided into two broad categories: natural and artificial.
The use of biological materials to replace synthetic polymers is on the rise as the environmental load from plastic waste becomes more obvious. The latest news comes from researchers at Harvard University who have developed a new material based on the protein collagen that could be used to make biodegradable plastic.
I've often used the phrase "bad biology" to describe how I view many of the supplements and products out there. I see bad biology as having three types of problems: 1. It's based on poor science or pseudoscience 2. It doesn't work 3. It has side effects or negative consequences.
the only place you need to go for all of your biology course needs. Our team of education experts has put together an outstanding collection of online biology courses, each one taught by a respected educator who can help you learn everything you need to know to succeed.
Biology Exploring Life is an advanced course that goes deeper into the subject and gives students the tools to develop a deeper understanding of life.
Life science is the study of living organisms including their structure, function, origins and evolution. Biology includes the study of cells (ranging from simple unicellular organisms like bacteria to complex multicellular organisms like humans), genetics, biochemistry, molecular biology and a whole lot more. A biology course is an important part of science education, which is a vital part of the modern education system.
An introductory biology course is a course designed for students who have not taken biology before. The main objective of an introductory biology course is to provide students with a general overview of the broad field of biology.
What's new in the latest Complete Biology Books 4.3.1
معلومات Biology Textbook APK
الإصدارات القديمة لـ Biology Textbook
Biology Textbook Complete Biology Books 4.3.1
قم بتنزيل سريع وآمن بالغاية عبر تطبيق APKPure
قم بتثبيت ملفات XAPK/APK بنقرة واحدة على أندرويد!